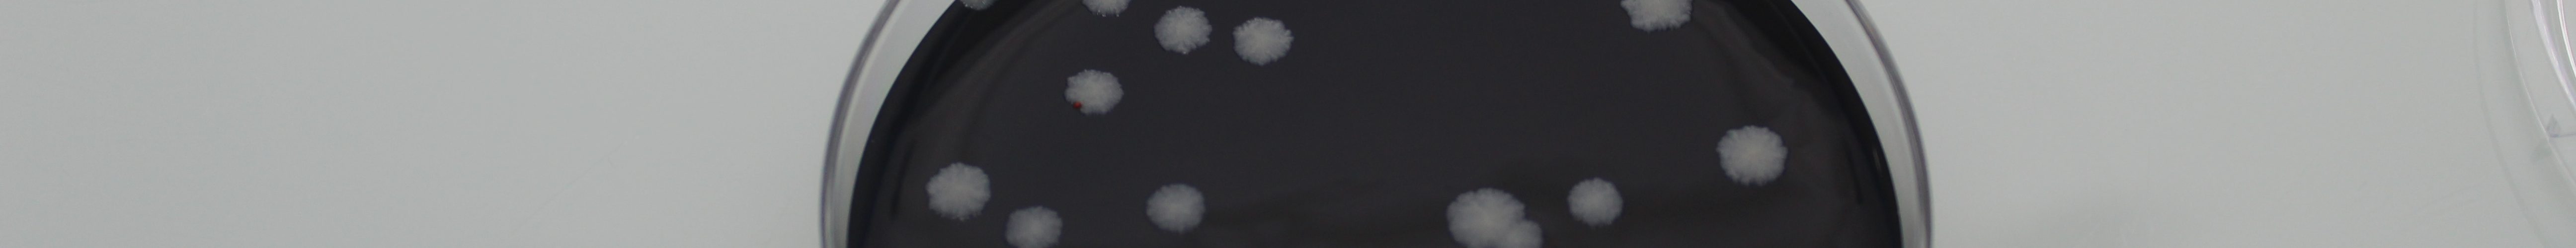

El laboratorio posee personal altamente cualificado y los recursos materiales y equipos más modernos para garantizar los estándares de calidad más exigentes.
Todos los servicios de la Empresa se encuentran amparados por Certificaciones de Gestión de la Calidad (ISO 9001:2015) y Gestión de la Calidad Ambiental (ISO 14001:2015). Así mismo, el laboratorio se encuentra acreditado por la Norma UNE 17025 . Consulte nuestro anexo técnico.
Nuestro laboratorio está especializado en análisis fisicoquímicos y microbiológicos de aguas, tanto las destinadas a consumo humano como a las aguas continentales en sus aplicaciones para piscinas, jacuzzis, fuentes ornamentales… El laboratorio se encuentra inscrito en el Catálogo de Laboratorios en el ámbito de la seguridad alimentaria y ambiental (Decreto 106/2010 del 25 de junio del Consell; Generalitat Valenciana